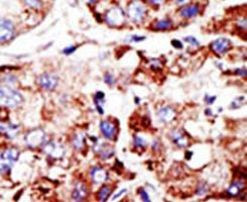
PIAS2 Antibody in Immunohistochemistry (IHC)

Search
Invitrogen
PIAS2 Polyclonal Antibody
{{$productOrderCtrl.translations['antibody.pdp.commerceCard.promotion.promotions']}}
{{$productOrderCtrl.translations['antibody.pdp.commerceCard.promotion.viewpromo']}}
{{$productOrderCtrl.translations['antibody.pdp.commerceCard.promotion.promocode']}}: {{promo.promoCode}} {{promo.promoTitle}} {{promo.promoDescription}}. {{$productOrderCtrl.translations['antibody.pdp.commerceCard.promotion.learnmore']}}
产品信息
PA5-11344
宿主/亚型
分类
类型
抗原
偶联物
形式
浓度
保存条件
运输条件
RRID
产品详细信息
This antibody is predicted to react with rat based on sequence homology.
靶标信息
This gene encodes a protein involved in the regulation of transcription factors involved in MAP kinase signaling. The symbol MIZ1 has also been associated with ZBTB17 which is a different gene located on chromosome 1. Two alternatively spliced transcripts encoding different isoforms have been described.
仅用于科研。不用于诊断过程。未经明确授权不得转售。